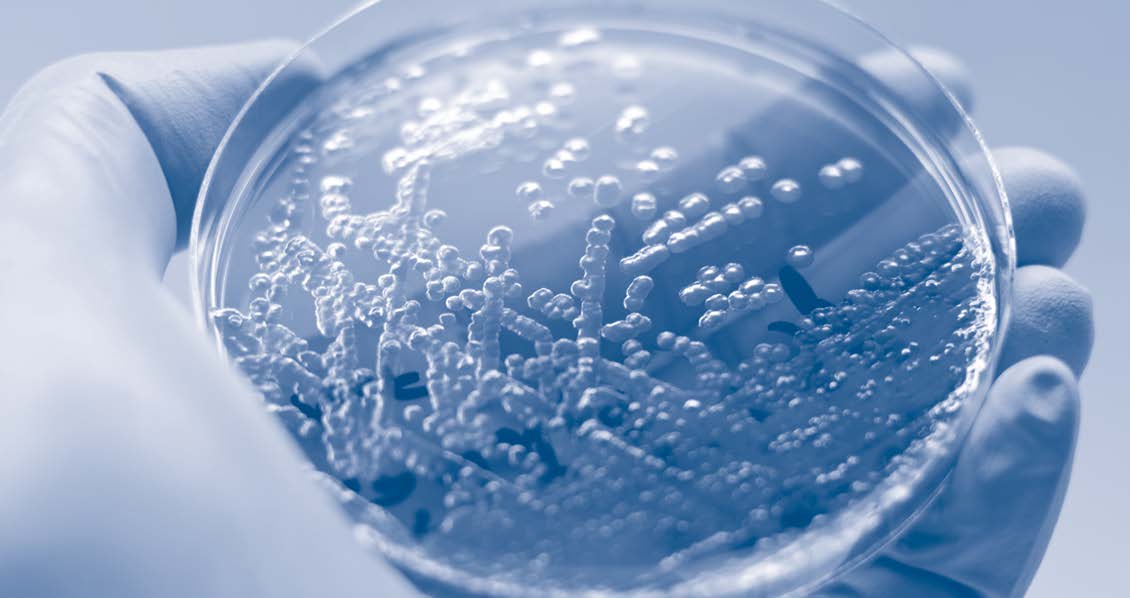

Maintenant en ligne
Blogue Santé Vous Bien
Le blogue Santé Vous Bien rassemble des articles accessibles et rigoureux sur la fibrose kystique et la vie avec la maladie, rédigés avec la collaboration de professionnel·le·s de la santé et des membres de la communauté.

10
sur
15
résultats
Value
Merci à nos partenaires























.jpg)